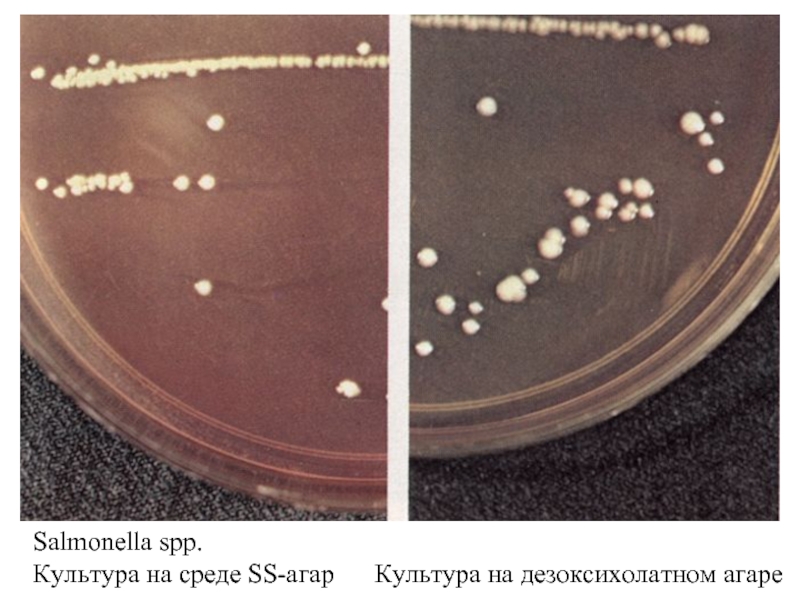

- Главная
- Разное
- Дизайн
- Бизнес и предпринимательство
- Аналитика
- Образование
- Развлечения
- Красота и здоровье
- Финансы
- Государство
- Путешествия
- Спорт
- Недвижимость
- Армия
- Графика
- Культурология
- Еда и кулинария
- Лингвистика
- Английский язык
- Астрономия
- Алгебра
- Биология
- География
- Детские презентации
- Информатика
- История
- Литература
- Маркетинг
- Математика
- Медицина
- Менеджмент
- Музыка
- МХК
- Немецкий язык
- ОБЖ
- Обществознание
- Окружающий мир
- Педагогика
- Русский язык
- Технология
- Физика
- Философия
- Химия
- Шаблоны, картинки для презентаций
- Экология
- Экономика
- Юриспруденция
Энтеробактерии. Сальмонеллы – возбудители брюшного тифа, паратифов и пищевой токсикоинфекции презентация
Содержание
- 2. CЕМЕЙСТВО БАКТЕРИЙ ENTEROBACTERIACEAE Роды :
- 3. ЭНТЕРОБАКТЕРИИ. Окраска по Граму.
- 4. Даниел Салмон (род назван в честь американского
- 5. Мазки из чистой культуры S. typhi.
- 6. Выделение культур энтеробактерий на среде Эндо
- 7. Salmonella spp. Культура на среде SS-агар Культура на дезоксихолатном агаре
- 9. Vi
- 10. Брюшной тиф. Розеолы на коже
- 12. БАКТЕРИОЛОГИЧЕСКИЙ: 1. выделение гемокультуры (1-я неделя
- 13. Р. иммунофлюоресценции Р. нейтрализации антител Р. нарастания
- 14. 1. обезвреживание источника инфекции (изоляция больного)
- 15. ЛЕЧЕНИЕ И ПРОФИЛАКТИКА САЛЬМОНЕЛЛЕЗНОЙ ИНФЕКЦИИ Лечение:
Слайд 2CЕМЕЙСТВО БАКТЕРИЙ ENTEROBACTERIACEAE
Роды : 1. Escherichia Палочковидные бактерии размером
2.
3. Shigella анаэробы. Грам -, подвижность ±,
4. Yersinia капсула ±. Оксидазоотрицательные.
5. Citrobacter Широко распространены в природе-
6. Klebciella в почве, воде, на растениях, в кишеч-
7. Enterobacter нике человека и животных.
8. Erwinia
9. Serratia -
10. Hafnia
11. Proteus 12. Providencia ,
13. Edwardsiella
14. Morganella
Из ран и при инфекциях мочевых путей часто выделяют бактерии родов Escherichia, Proteus, Enterobacter, Klebsiella и др.
Слайд 4Даниел Салмон
(род назван в честь американского
исследователя Д. Салмона)
РОД SALMONELLA
ВИД:
S. bongori
ПОДВИДЫ:
choleraesuis
salamae
arizonae
diarizonae
houtenae
indica
Слайд 5 Мазки из чистой культуры S. typhi. Окраска по Граму.
S. typhi
Слайд 12БАКТЕРИОЛОГИЧЕСКИЙ:
1. выделение гемокультуры (1-я неделя болезни)(Г.Конради,1906 г)
2. выделение копро-,
СЕРОЛОГИЧЕСКИЙ:
А) для обнаружения антител:
1. реакция пассивной гемагглютинации (РПГА)-
2. р. агглютинации Видаля
3. иммуноферментный анализ (ИФА)
Б) для выявления антигенов:
1. р. иммунофлюоресценции
2. ИФА
радиоиммунный анализ (РИА)
АЛЛЕРГИЧЕСКИЙ: - внутрикожная проба с эбертином
МЕТОДЫ ДИАГНОСТИКИ БРЮШНОГО ТИФА
Слайд 13Р. иммунофлюоресценции
Р. нейтрализации антител
Р. нарастания титра фага
Молекулярное зондирование.
ЭКСПРЕСС – ДИАГНОСТИКА
ДИАГНОСТИКА БАКТЕРИОНОСИТЕЛЬСТВА ПРИ БРЮШНОМ ТИФЕ
Выделение копро-, урино- и били – культур
Р. прямой иммунофлюоресценции для выявления возбудителя
Р. непрямой гемагглютинации (РНГА) с Vi –антигеном для обнаружения антител
Аллергическая проба с Vi-тифином
Слайд 141. обезвреживание источника инфекции (изоляция больного)
2. пресечение путей передачи:
- медицинское
- прием бактериофагов;
- выявление бактерионосителей;
- диспансерное наблюдение за переболевшими (2 года);
- упорядочение центрального водоснабжения и канализационной системы, рациональная очистка сточных вод, благоустройство населенных пунктов, борьба с мухами, санитарно-просветительная работа, санитарный контроль за изготовлением, хранением, транспортировкой и реализацией пищевых продуктов;
3. специфическая вакцинация:
- в РФ – 1. тифивак – вакцина спиртовая сухая цельноклеточная инактивированная; 2. вианвак – Vi- полисахаридная, жидкая вакцина
- за рубежом – жидкая живая пероральная вакцина из мутанта Т у21а;
- Vi-полисахаридная вакцина;
- генно-инженерные вакцины (в стадии разработки).
ПРОФИЛАКТИКА ТИФО – ПАРАТИФОЗНЫХ ИНФЕКЦИЙ
Слайд 15ЛЕЧЕНИЕ И ПРОФИЛАКТИКА САЛЬМОНЕЛЛЕЗНОЙ ИНФЕКЦИИ
Лечение:
патогенетическая терапия, направленная на уменьшение интоксикации,
Профилактика:
Методы специфической профилактики не разработаны;
Основное значение имеют:
ветеринарно-санитарные меры, направленные на ограничение роли источников инфекции;
санитарно-гигиенический надзор, направленный на обеззараживание факторов передачи инфекции и предупреждение обсеменения сальмонеллами пищевых продуктов на всех этапах их производства и реализации